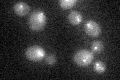
YMR168C
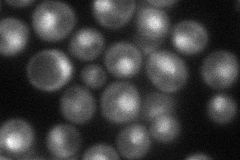
YMR168C
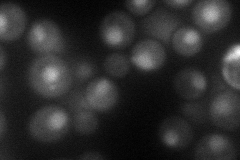
YMR168C
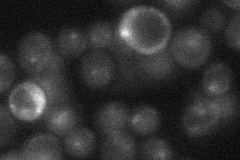
YMR168C
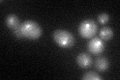
YMR168C

View description
Essential kinetochore protein, component of the CBF3 complex that binds the CDEIII region of the centromere; contains an N-terminal Zn2Cys6 type zinc finger domain, a C-terminal acidic domain, and a putative coiled coil dimerization domain
Localization:
Intensity:
Fold change:
Significance:
-
C’ GFP library in SD
punctate25.1 -
N' NOP1pr-GFP in SD
punctate,nucleus52.9762 -
N' TEF2pr-mCherry in SD
nucleus54.4228 -
N' NATIVEpr-GFP in SD
punctate,nucleus24.1817 -
N' TEF2pr-VC and Cyto-VN in SD

#N/A0 -
C’ GFP library in SD+DTT
punctate23.80.94No -
C’ GFP library in SD+H2O2

punctate24.120.96No -
C’ GFP library in Starvation Media

punctate22.80.9No -
C’ GFP library on the background of Pup2-DaMP

punctate -
C’ GFP library on the background of CCT mutant

punctate27.35821.08957No
